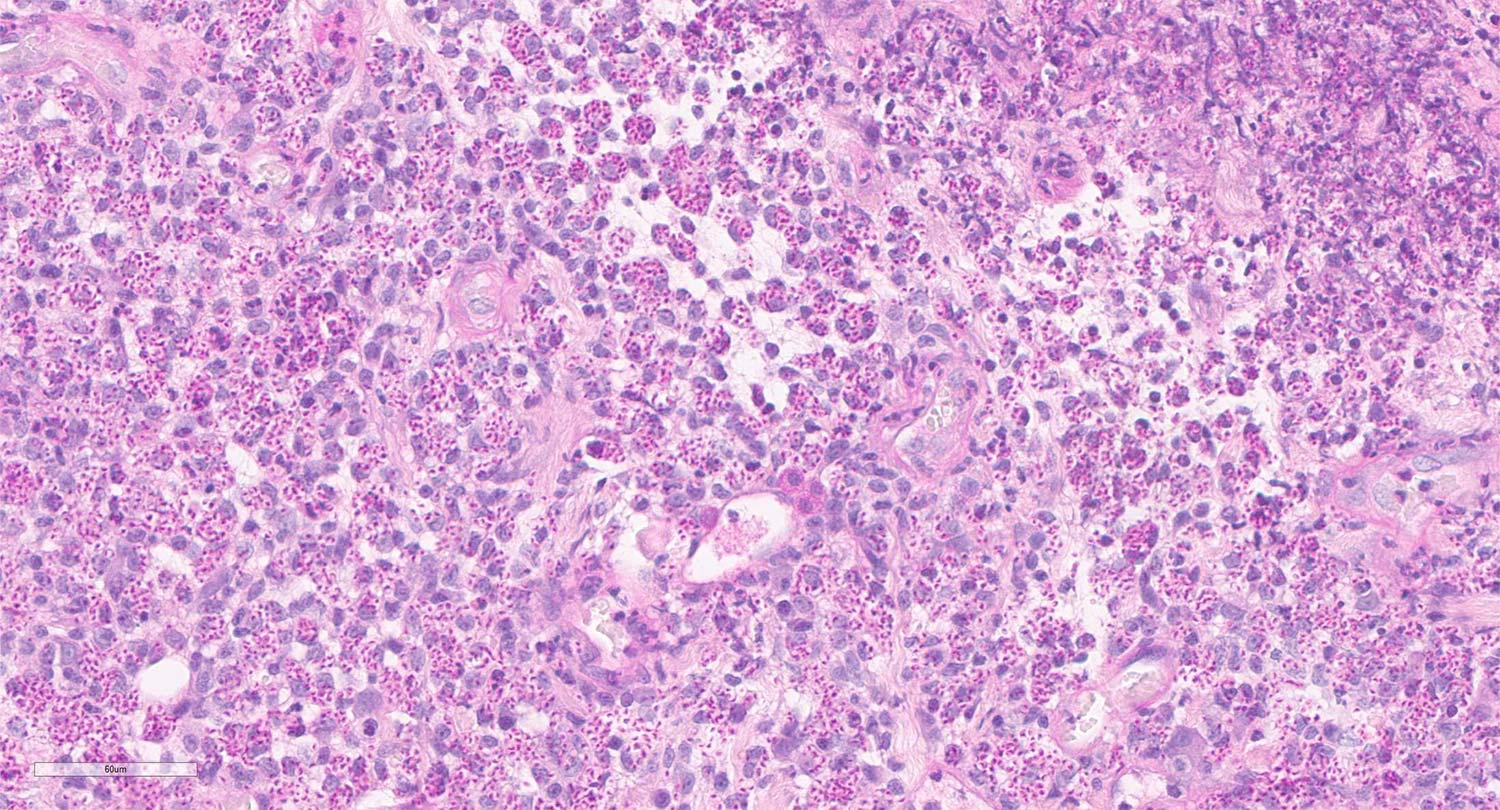

Epidemiologie & Bedeutung
Sporothrix sp. sind saprophytäre Pilze, die im feuchten organischen Milieu (z. B. Erde, Heu, Wasser) in Myzelform vorkommen. Es handelt es sich um opportunistische Erreger von Mykosen. Pathogenetisch bedeutsam sind 4 Spezies des Sporothrix (S.) schenkii Komplexes: S. schenkii, S. brasiliensis, S. globosa und S. luriei. S. schenkii ist weltweit verbreitet und die am häufigsten in Mitteleuropa nachgewiesene Spezies, während S. brasiliensis in einigen Ländern Südamerikas endemisch ist und dort ein erhebliches Gesundheitsrisiko für Mensch und Tier darstellt.
Erkrankungen bei Tieren wie Hunden, Katzen, Pferden und Menschen treten am häufigsten in den gemäßigten und tropischen Klimazonen auf. In Europa ist die Prävalenz bislang niedrig und es handelt sich in der Regel um Infektionen mit Sporothrix schenkii.
Menschen können sich durch Wundkontaminationen (Hautverletzungen z. B. durch kontaminierte Erde, Dornen, Holzsplitter) infizieren. Weiterhin stellen infizierte Katzen (über Kratz- oder Bisswunden oder direkten Kontakt mit Sekreten) eine weitere wichtige Infektionsquelle dar. Die Sporotrichose ist daher als relevante Zoonose einzustufen und geeignete Schutzmaßnahmen sind anzuraten.
Krankheitsbild der felinen Sporotrichose
Die feline Sporotrichose tritt am häufigsten bei intakten männlichen Freigänger-Katzen auf, infolge von Kratz- oder Bisswunden durch infizierte Katzen (asymptomatische Carrier möglich!). Typische Lokalisationen sind Kopf, Gliedmaßen und Schwanzbasis (häufige Angriffsziele bei Kämpfen).
Selten kann auch eine Inhalation der Erreger zu Infektionen führen.
Es existieren 3 klinische Formen: kutan, mukokutan und disseminiert. Die Mehrzahl der Fälle ist auf die Haut und das subkutane Fettgewebe beschränkt, teils unter Einbeziehung der Lymphknoten. Die mukokutane Form ist gekennzeichnet durch eine zusätzliche Schleimhautbeteiligung (nasal, konjunktival, oral, genital). Bei der selteneren disseminierten Form kommt es zur systemischen Ausbreitung des Erregers: es können Organe (insbesondere Lunge) und Knochen betroffen sein.
Bei der kutanen Form finden sich multifokale, erhabene, krustöse und haarlose Plaques und Knoten, die häufig ulzeriert sind (Abb. 1). Oft ist eine Beschränkung der Läsionen auf den Bereich der Eintrittspforte des Erregers zu beobachten, da eine intakte Wirtsabwehr eine weitere Ausbreitung im Organismus verhindert. Allerdings kann es durch hämatogene Erregerverbreitung (u. a. sekundär bei einer primär respiratorischen Form) oder im Rahmen der Fellpflege auch zu großflächigeren kutanen Ausbreitungen kommen.
Auch wenn Infektionen in Europa selten sind, sollte besonders bei Katern mit Freigang und ulzerativen Hautläsionen auch an eine Sporotrichose gedacht werden, insbesondere wenn zunächst eine bakterielle Ursache angenommen wurde und eine Antibiose nicht erfolgreich war. Einige mögliche Differentialdiagnosen sind in Tabelle 1 zusammengestellt.
-
Abb. 1: hochgradige noduläre und ulzerative Hautläsionen einer Katze mit Sporotrichose
Bildquelle: Kleintierambulanz DonauVet
-
Abb. 2A: histologische Übersicht einer nodulären Hautläsion, zu sehen ist eine Ulzeration und darunter eine hochgradige granulomatöse Entzündung (HE-Färbung, 2-fache Vergrößerung, Maßstab 800 µm)
Bildquelle: Laboklin
-
Abb. 2B: histologisches Detail: hochgradige granulomatöse Entzündung mit zahlreichen, überwiegend intrazytoplasmatisch
in Makrophagen gelegenen Sporothrix-Erregern (Hefeform, PAS-Reaktion, 40-fache Vergrößerung, Maßstab 60 µm)
Bildquelle: Laboklin
Da es sich bei der Sporotrichose um eine Zoonose handelt, sollte das Handling von Katzen mit ulzerativen Hautläsionen ausschließlich mit Schutzkleidung und medizinischen Handschuhen erfolgen und auf eine Prävention von Kratz- und Bissverletzungen geachtet werden. Zu beachten ist, dass auch einige der in Tabelle 1 aufgelisteten Erreger zoonotisches Potential besitzen.
Tabelle 1: Beispiele für mögliche Differentialdiagnosen bei nodulären und ulzerativen Hautläsionen der Katze (nicht vollständig!)
| Erreger/Erkrankung | Klinisches Bild | Lokalisation Hautläsionen |
| Sporothrix sp. | multiple krustöse Plaques und Knoten, +/- Ulzeration; mukokutane/systemische Formen möglich | i. d. R. Kopf, Gliedmaßen, Schwanzbasis (Kampfverletzungen!), Ausbreitung möglich |
| Andere invasive Pilzinfektionen (in Mitteleuropa v. a. Kryptokokkose) | solitäre/multiple kutane Knoten und Abszesse, +/- Ulzeration; oft systemisch | Gesicht, Pinna, Pfoten |
| Microsporum canis
|
i. d. R. oberflächliche Dermatophytose mit kreisrunder Alopezie, Schuppen und Erythem („ringworm“); selten invasive Formen: noduläre Granulome (Pseudomyzetome) | vor allem Kopf, teils auch andere Regionen wie distale Gliedmaßen und Schwanz |
| Kuhpocken-Infektion | Plaques, Ulzerationen, Krusten | Kopf, Hals, Vordergliedmaßen |
| Feline Lepra ( Mycobacterium lepraemurium) | multiple, kutane und subkutane Knoten, +/- Ulzeration | Meist Kopf und Vordergliedmaßen (Übertragung durch Rattenbisse) |
| Neoplasien | Solitäre oder multiple kutane/subkutane Umfangsvermehrungen, +/- Ulzeration |
variabel |
Für den klinischen Verlauf und das zoonotische Potential ist das komplexe Zusammenspiel aus Virulenzfaktoren bzw. Pathogenität des Erregers (Sporothrix brasiliensis > Sporothrix schenkii) einerseits und prädisponierenden Wirtsfaktoren andererseits entscheidend. So kann eine durch Retrovirusinfektionen oder Corticosteroidtherapie bedingte Immunsuppression eine wegbereitende Rolle spielen. Weitere Faktoren wie eine regelmäßige Entwurmung können mit einer besseren Immunantwort und damit mit milderen Verlaufsformen und geringerem zoonotischen Potential einhergehen. Disseminierte Erkrankungsformen sind selten und können sich in Abhängigkeit von den oben genannten Faktoren aus kutan-lymphatischen Formen oder auch infolge einer Inhalation des Erregers entwickeln. Symptome systemischer Erkrankungen sind oft unspezifisch (Fieber, Abgeschlagenheit, Anorexie), bei Beteiligung der Atemwege auch respiratorisch (Niesen, Nasenausfluss, Dyspnoe). Respiratorische Symptome können auch vor dem Auftreten von Hautläsionen oder auch ohne äußere Veränderungen zu beobachten sein.
Diagnostik
Wenn aufgrund nodulärer bzw. ulzerativer Hautläsionen eine Sporotrichose auf der differentialdiagnostischen Liste steht, sind die folgenden diagnostischen Methoden sinnvoll.
Zytologie
Die Zytologie stellt eine relativ sensitive diagnostische Methode zur Visualisierung von Sporothrix dar. In Ausstrichen von Abklatschpräparaten der ulzerierten Hautläsionen oder Feinnadelaspiraten aus den Knoten können die Hefen in der zytologischen Übersichtsfärbung (z. B. Romanowsky) oder mittels Spezialfärbung (wie PAS-Reaktion) dargestellt werden.
Verdächtige Präparate sollten zur Bestätigung des Verdachts weiterführend kulturell untersucht werden.
Histologie
Die histopathologische Untersuchung ist sinnvoll bei nichtulzerierten Hautknoten. Histopathologisch stellt sich die feline Sporotrichose als diffuse oder (multi-)noduläre pyogranulomatöse Dermatitis und Pannikulitis dar, mit variabel ausgeprägten Ulzerationen und Nekrosen. Die Läsionen enthalten in der Regel zahlreiche Erreger. Im Gewebe liegen Sporothrix sp. als Hefeform von pleomorpher bis runder oder zigarrenförmiger Gestalt vor, die in nekrotischen Arealen frei im Gewebe oder im Zytoplasma von Makrophagen zu beobachten sind.
Mithilfe weiterführender Spezialfärbungen (PAS-Reaktion, Grocott Färbung) lassen sich die Hefen noch deutlicher darstellen, insbesondere, wenn nur wenige Erreger vorhanden sind.
Kultur
Die Kultur stellt die Diagnostikmethode der Wahl zur Bestätigung von Verdachtsfällen dar. Dabei sollte dem Labor der klinische Verdacht unbedingt vorberichtlich mitgeteilt werden, da die Sporotrichose selten ist.
Als Proben eignen sich Exsudate (möglichst aus der Tiefe der Hautläsionen gewonnen) oder besser Gewebeproben, um falsch negative Ergebnisse zu vermeiden. Im Fall disseminierter Formen ist eine Blutkultur sinnvoll. Bei respiratorischen Formen sind weitere mögliche Proben für eine Kultur Nasenabstriche oder eine bronchoalveoläre Lavage.
Die größte diagnostische Sicherheit bietet eine histologische Untersuchung einschließlich Spezialfärbungen in Kombination mit einer mykologischen Kultur.
Spezifische Nachweisverfahren wie PCR werden von Speziallaboren angeboten.
Therapie & Prognose
Für die Behandlung der kutanen Form der felinen Sporotrichose hat sich in erster Linie die systemische Therapie mit Itraconazol über mindestens zwei Monate bzw. einen Monat über die klinische Heilung hinaus bewährt.
Einen detaillierten Therapie-Leitfaden finden Sie z. B. im unten genannten Artikel von Rodrigues et al.
Entscheidend für die Prognose ist insbesondere die Besitzercompliance. Bei konsequenter Behandlung und sofern keine Nebenwirkungen der eingesetzten Medikamente auftreten, ist die Prognose gut. Disseminierte Infektionen oder zu frühes Absetzen der Therapie sind hingegen mit einer ungünstigen Prognose verbunden.
Dr. Karen Lampe
Unsere Leistungen rund um die Sporotrichose:
- Zytologie
- Pathohistologie (einschließlich Spezialfärbungen)
- Mykologie
Weiterführende Literatur
-
Barrs VR, Beczkowski PM, Talbot JJ, Hobi S, Teoh SN, Muguiro DH, Shubitz LF, Sandy J. Invasive fungal infections and oomycoses in cats. 1. Diagnostic approach. J Fel Med Surg. 2024 Jan. 26 (1-22): doi: 10.1177/1098612X231219696
-
Gremião IDF, Miranda LHM, Reis EG, Rodrigues AM, Pereira SA. Zoonotic epidemic of sporotrichosis: cat to human transmission. PLoS pathogens, 2017 Jan. 13(1), doi:10.1371/1006077
-
Lloret A, Hartmann K, Pennisi MG, Ferrer L, Addie D, Belak S, Boucraut-Baralon C, Egberkink H, Frymus T, Gruffydd-Jones T, Hosie MJ, Lutz H, Marsilio F, Möstl K, Radford AD, Thiry E, Truyen U, Horzinek MC. Sporotrichosis in cats. ABCD guidelines on prevention and management. J Fel Med Surg. 2013 Jun. 15 (619-623): doi: 10.1177/1098612X13489225
-
Rodrigues EMF, Passos Cortez L, Passos Cortez L, Oliveira da Costa RC, Barbosa Costa S, Bezerra de Morais N, Ferreira TC. Advances in the therapeutic approaches to feline sporotrichosis: a review. Rev Bras Hig San Anim. 2025 Jun. 19 (1): 2. doi: 10.5935/1981-2965.20240042